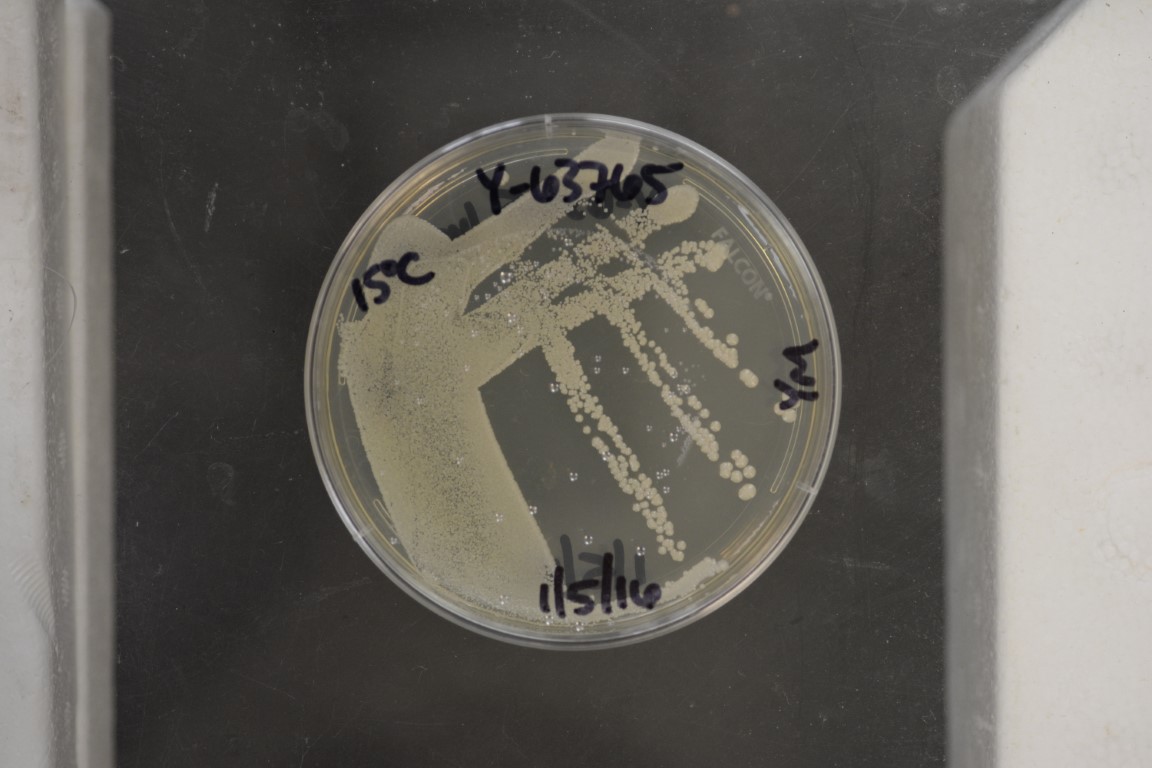

Kazachstania psychrophila
NRRL Y-63765(Type Strain)
Accession numbers in other collections:CBS 12689=DSM 26230=H433
Source:C.P.Kurtzman,NCAUR-->CBS
Isolated from(substrate):MFD,beef
Substrate location:Kulmbach,Bavaria,Germany
Genetic info:GenBank:D1/D2(JX564243).
Growth media:Yeast Extract-Malt Extract-Peptone-Glucose(YM for yeasts)(number 6)
Optimum growth temperature:15C
Strain images:
NRRL_Y-63765_6.jpg

Comments:MycoBank MB 803980